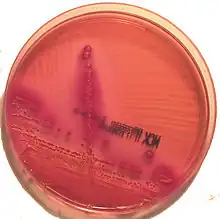

Gélose MacConkey

La gélose MacConkey est un milieu de culture sélectif et différentiel employé en microbiologie pour l'isolement et l'identification des bacilles Gram négatifs (BGN). Ce milieu comporte un indicateur coloré qui détecte la consommation du lactose. Développé dans les années 1900 par A.T. MacConkey pour faciliter l'identification de Escherichia coli dans les eaux, les sols et les aliments[1],[2], il est très utilisé pour isoler les BGN dans toutes sortes de prélèvements polymicrobiens.
Principe
La base nutritive se compose de lactose et d'un mélange de trois peptones : peptone pancréatique de gélatine, de caséine et peptone peptique de viande.
La sélectivité du milieu provient principalement de la présence de deux inhibiteurs, les sels biliaires et le violet de gentiane, qui s'opposent à la croissance des bactéries Gram positives. Les nutriments sont insuffisants pour permettre la croissance des cocci Gram négatifs (Neisseria surtout).
Le rouge neutre est un indicateur de pH de couleur rouge dans la gamme de pH initiale du milieu. Il permet la lecture du caractère lactose : les bactéries qui métabolisent ce disaccharide le convertissent en sous-produits acides, entraînant un virage au rouge de l'indicateur.
Le chlorure de sodium augmente la pression osmotique au sein du milieu. L'agar est l'agent gélifiant.
Lecture
Les colonies qui présentent le caractère lactose (colonies « lactose + ») sont colorées en rose à rouge et rougissent le milieu environnant. Elles peuvent être entourées d'un halo opaque provoqué par la précipitation des sels biliaires en milieu acide.
Les autres colonies sont incolores et ne modifient pas l'aspect du milieu en périphérie.
Composition
Pour 1000 mL de milieu[3],[4] :
- peptone pancréatique de gélatine : 17 g
- peptone pancréatique de caséine : 1,5 g
- peptone peptique de viande : 1,5 g
- lactose : 10 g
- chlorure de sodium : 5 g
- sels biliaires : 1,5 g
- rouge neutre : 30 mg
- violet de gentiane : 1 mg
- agar : 13,5 g.
Ajuster le pH à 7,1 ± 0,2 à 25°C (après autoclavage).
La composition peut varier d'un fabricant à l'autre : les trois sortes de peptones peuvent être remplacées par 20 g/L d'une peptone quelconque, et la concentration d'agar peut varier entre 1,2 et 1,5% (m/v). En fonction du type de sels biliaires utilisés (n°2 ou n°3) on peut trouver dans le commerce des géloses MacConkey n°2 ou n°3.
La gélose MacConkey sorbitol ou SMAC (de l'anglais Sorbitol MAcConkey agar) est une variante dans laquelle le lactose est remplacé par une masse identique de sorbitol, un polyol à 6 atomes de carbone. Ainsi modifié, ce milieu est utile à la détection des Escherichia coli du sérotype O157:H7 dont la pathogénicité particulière est liée à la production de shigatoxines (STEC). En effet les E. coli O157:H7 se distinguent par leur incapacité à acidifier le sorbitol qui se traduit par la formation de colonies incolores sur la gélose SMAC, tandis que les E.coli ordinaires acidifient le sorbitol et forment donc des colonies rouges. Cependant ce caractère n'a qu'une valeur d'orientation, la confirmation de l'identification devant être apportée par une technique plus précise telle qu'un sérotypage (dirigé contre les antigènes O157 et H7) ou une PCR.
Préparation
Aucun ingrédient n'étant thermosensible, il suffit de les dissoudre à chaud dans le volume correspondant d'eau distillée et de stériliser à l'autoclave (15 min à 121°C). Le mélange est ensuite réparti dans des contenants stériles.
Notes et références
- ↑ MacConkey AT « Note on a new medium for the growth and differenciation of the Bacillus coli communis and the Bacillus typhi abdominalis » Lancet 1900;156(4010):20. https://doi.org/10.1016/S0140-6736(01)99513-3
- ↑ MacConkey AT « Lactose-fermenting bacteria in faeces » J Hyg (Lond). 1905;5(3)333-379. https://doi.org/10.1017/S002217240000259X
- ↑ https://www.bd.com/resource.aspx?IDX=8826, consulté le 06/05/21.
- ↑ https://himedialabs.com/TD/M081B.pdf, consulté le 09/05/21.
Voir aussi
- Milieu de culture
- Liste de milieux de culture
- Portail de la microbiologie